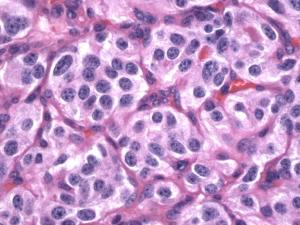

apud系统,APUD系统的概述
时间:2024-11-03 来源:网络 人气:
APUD系统的概述

APUD系统,全称为胺前体摄取和脱羧系统(amine precursor uptake and decarboxylation),是人体内一种重要的内分泌系统。该系统由一系列内分泌细胞组成,这些细胞能够摄取生物胺前体,并在细胞内通过脱羧作用产生生物胺和多肽激素。APUD系统在人体内广泛分布,几乎存在于所有脏器中,对维持人体生理功能具有重要意义。
APUD系统的来源与分布
APUD细胞起源于胚胎神经嵴,在胚胎发育过程中逐渐分化成各种内分泌细胞。这些细胞在人体内广泛分布,包括中枢神经系统、周围神经系统、消化系统、呼吸系统、泌尿生殖系统等。其中,APUD细胞在消化系统中的分布尤为丰富,如胃、肠、胰腺等器官中均存在APUD细胞。
APUD系统的功能与作用

APUD系统在人体内发挥着多种生理功能,主要包括以下几个方面:
合成和分泌生物胺和多肽激素:APUD细胞能够摄取生物胺前体,通过脱羧作用产生相应的生物胺和多肽激素,如5-羟色胺、多巴胺、肾上腺素等。
调节神经系统功能:APUD细胞在神经系统中的分布与神经递质的合成和释放密切相关,对神经系统功能具有调节作用。
调节消化系统功能:APUD细胞在消化系统中的分布与消化酶的分泌、胃肠道运动等功能密切相关,对消化系统功能具有调节作用。
参与免疫调节:APUD细胞在免疫系统中的分布与免疫细胞的增殖、分化等功能密切相关,对免疫系统具有调节作用。
APUD系统与疾病的关系

APUD瘤:APUD系统细胞发生的肿瘤,如嗜铬细胞瘤、甲状腺髓样癌、胰岛细胞瘤等。
内分泌失调:APUD系统细胞功能异常可能导致内分泌失调,如甲状腺功能亢进、糖尿病等。
神经系统疾病:APUD系统细胞在神经系统中的分布与神经系统疾病的发生和发展密切相关,如帕金森病、阿尔茨海默病等。
APUD系统的诊断与治疗

针对APUD系统相关的疾病,诊断和治疗措施主要包括以下几方面:
诊断:通过实验室检查、影像学检查、病理学检查等方法,对APUD系统相关的疾病进行诊断。
治疗:根据疾病类型和严重程度,采取相应的治疗方法,如手术治疗、药物治疗、放疗等。
APUD系统是人体内一种重要的内分泌系统,在维持人体生理功能方面发挥着重要作用。了解APUD系统的来源、分布、功能、作用以及与疾病的关系,有助于我们更好地预防和治疗相关疾病。随着医学技术的不断发展,对APUD系统的深入研究将为人类健康事业做出更大贡献。
教程资讯
教程资讯排行













